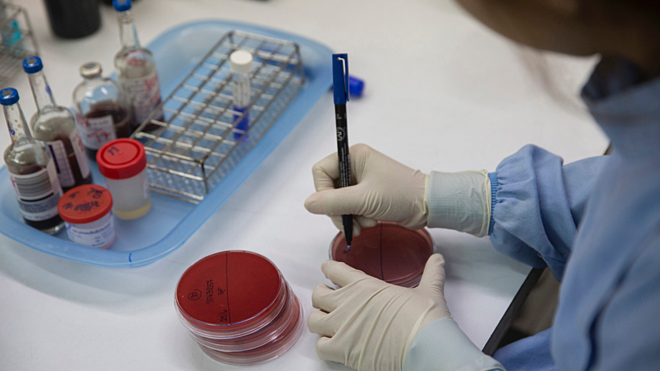
Dấu hiệu nào cho thấy bạn đã bị nhiễm vi khuẩn whitmore? ảnh 2

Chỉ trong tháng 8/2019, Trung tâm Bệnh nhiệt đới, BV Bạch Mai đã tiếp nhận 12 ca mắc Whitmore (tên người tìm ra bệnh), trong đó có 4 ca đã tử vong.
Mới đây, Trung tâm Bệnh Nhiệt đới, Bệnh viện Bạch Mai lần đầu tiên tiếp nhận một bệnh nhân nữ mắc whitmore khá hy hữu, với trình trạng vi khuẩn whitmore ăn cánh mũi.
Trước khi đến bệnh viện, bệnh nhân được chẩn đoán bị nhiễm trùng huyết do tụ cầu nhưng tại Trung tâm bệnh Nhiệt đới - Bệnh viện Bạch Mai, cấy máu và mủ ở vết thương cho kết quả dương tính với vi khuẩn whitmore.
Đến nay, bệnh Whitmore vẫn chưa có vắc-xin phòng bệnh. Bệnh có thể gây tử vong cao, với tỷ lệ tử vong có thể lên đến 40-60%. Tuy nhiên, nếu bệnh nhân được chẩn đoán xét nghiệm sớm và điều trị kháng sinh phù hợp thì tỷ lệ tử vong sẽ giảm đi đáng kể.
Bệnh whitmore là gì?
Whitmore còn gọi bệnh melioidosis, là bệnh truyền nhiễm cấp tính nguy hiểm do vi khuẩn Burkholderia pseudomallei gây nên. Căn bệnh này được phát hiện đầu tiên trên thế giới vào năm 1911.
Vi khuẩn B. pseudomallei sống trong đất, vì thế đường lây nhiễm chính là qua tiếp xúc các vết trầy xước trên da với đất hoặc nước có vi khuẩn. Lây nhiễm qua đường hô hấp khi hít phải các hạt bụi đất có vi khuẩn trong những trận gió lốc xoáy trước cơn mưa.
 Hình dạng của vi khuẩn B. pseudomallei. - Ảnh: Vietnamnet |
Một số nghiên cứu cho thấy có thể nhiễm bệnh khi ăn thức ăn có vi khuẩn. Chưa có bằng chứng về lây bệnh giữa người với người hoặc lây từ động vật sang người qua đường không khí. Vì thế, các ca bệnh Whitmore thường lác đác, lẻ tẻ chứ không bùng phát thành dịch hoặc đại dịch.
Bệnh lưu hành chủ yếu tại vùng nhiệt đới, đặc biệt là các quốc gia Đông Nam Á, phổ biến nhất là Thái Lan, Malaysia, Singapore và bắc Australia.
Tại vùng đông bắc Thái Lan, nghiên cứu năm 2009 do Trung tâm kiểm soát và phòng ngừa dịch bệnh Hoa Kỳ (CDC Hoa Kỳ) phối hợp thực hiện cho thấy, tỉ lệ mắc whitmore trong dân số là 14,9/100.000 người, trong đó nam giới chiếm 60%.
Thời gian ủ bệnh whitmore từ 1-21 ngày, trung bình 9 ngày nhưng cũng có trường hợp chỉ vài giờ. Trong giai đoạn này thường không có triệu chứng. Các triệu chứng thường xuất hiện hai đến bốn tuần sau khi tiếp xúc vi khuẩn.
Bệnh thường xuất hiện nhiều vào mùa mưa ẩm. Vi khuẩn có thể sống nhiều năm trong đất và nước bị ô nhiễm.
Loại vi khuẩn này cũng được coi là mối nguy tiềm tàng dẫn tới chiến tranh sinh học hay khủng bố sinh học. Đến nay, B. pseudomallei là một trong những vi khuẩn có bộ gene di truyền phức tạp nhất.
Người khoẻ mạnh cũng có thể mắc whitmore nhưng những trường hợp có hệ miễn dịch suy yếu như người nhiễm HIV, ung thư, bệnh phổi tắc nghẽn mãn tính, bệnh gan, thalassemia, tiểu đường, bệnh thận... sẽ có nguy cơ nhiễm bệnh cao hơn.
Dấu hiệu bệnh whitmore
MedicineNet chia bệnh melioidosis thành các loại khác nhau, mỗi loại có dấu hiệu và triệu chứng riêng:
Nhiễm trùng phổi: Các dấu hiệu và triệu chứng của melioidosis phổ biến nhất, xuất phát từ bệnh phổi nơi nhiễm trùng có thể hình thành một khoang mủ (áp xe). Tác động của nhiễm trùng phổi có thể từ viêm phế quản nhẹ đến viêm phổi nặng. Do đó, bệnh nhân cũng có thể bị sốt, nhức đầu, chán ăn, ho, khó thở, đau ngực và đau nhức cơ nói chung.
Nhiễm trùng cục bộ: Khi nhiễm trùng trên da (viêm mô tế bào) sẽ có các dấu hiệu như đau hoặc sưng, loét và áp xe, kèm theo sốt và đau cơ.
Nhiễm trùng máu: Nếu melioidosis xâm nhập vào máu, các triệu chứng có thể bao gồm sốt, nhức đầu, suy hô hấp, khó chịu ở bụng, đau khớp và mất phương hướng.
Nhiễm trùng lan tỏa: Bệnh melioidosis có thể lây lan từ da qua máu để trở thành một dạng melioidosis mạn tính ảnh hưởng đến tim, não, gan, thận, khớp và mắt.
Nhìn chung, bệnh nhân nhiễm vi khuẩn Whitmore thường sốt, giảm cân, đau dạ dày hoặc ngực, đau cơ khớp, đau đầu và co giật.
Để chẩn đoán bệnh whitmore, bác sĩ phải thực hiện phân lập vi khuẩn từ máu, đờm, nước tiểu, dịch áp xe của bệnh nhân. Trong một số trường hợp, bác sĩ có thể sử dụng xét nghiệm kháng thể trong máu để chẩn đoán bệnh nhưng độ tin cậy thấp hơn so với cấy vi khuẩn.
Điều trị whitmore
Chẩn đoán bệnh Whitmore chính xác phải dựa trên các xét nghiệm phân lập và định danh vi khuẩn trong mẫu bệnh phẩm máu, mủ, đờm, nước tiểu hoặc dịch não tủy. Ảnh: Vnexpress. |
Tuỳ từng loại nhiễm trùng, bác sĩ sẽ chỉ định dùng thuốc thích hợp để điều trị whitmore. Thông thường, điều trị chia làm 2 đợt: Đợt 1, tấn công bằng kháng sinh liều cao (thường truyền tĩnh mạch) trong 10-14 ngày. Đợt 2, dùng kháng sinh đường uống duy trì trong 3-6 tháng kế tiếp.
2 loại kháng sinh truyền tĩnh mạch điều trị whitmore phổ biến nhất là Ceftazidime, dùng mỗi 6-8 giờ hoặc Meropenem dùng mỗi 8 giờ. Các loại kháng sinh đường uống bao gồm: Trimethoprim-sulfamethoxazole hoặc Amoxicillin / axit clavulanic (co-amoxiclav) được thực hiện mỗi 8 giờ. Với những bệnh nhân nặng, bác sĩ có thể kết hợp cùng lúc nhiều loại thuốc.
Với những bệnh nhân áp xe phổi, nếu sau 6 tháng, bệnh nhân vẫn còn khối áp xe, khi đó bác sĩ sẽ xem xét phẫu thuật cắt bỏ.
Nếu bệnh nhân không tuân thủ điều trị, nguy cơ tái phát vẫn có thể xảy ra, khi đó tiên lượng điều trị sẽ khó khăn hơn nhiều.
Khi nhiễm whitmore, nếu không được điều trị sớm, bệnh nhân sẽ diễn tiến nặng dẫn tới nhiễm trùng huyết, sốc nhiễm trùng rồi tử vong. Tỉ lệ tử vong chung khi nhiễm whitmore là 40%.
Cách phòng ngừa bệnh
Hiện nay chưa có vắc xin phòng bệnh whitmore, nên phòng bệnh cần được trú trọng. Do vi khuẩn thường có trong bùn đất, nước nên người dân, đặc biệt là các đối tượng nguy cơ cao cần hạn chế tiếp xúc trực tiếp với đất hoặc nước ô nhiễm. Nông dân khi làm đồng nên đeo ủng, găng tay.
































